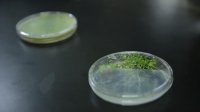

Guanajuato, Gto., a 19 de diciembre de 2025.- El Mtro. en Ciencias Biológicas y doctorante en esta misma rama, por la Universidad de Guanajuato (UG), Francisco Vargas Gasca, fue reconocido por presentar una de las tres mejores charlas estudiantiles durante el XV Congreso de Biología Molecular y Celular de Hongos, realizado en Mérida, Yucatán, en donde planteó el potencial de utilizar hongos para sustituir pesticidas en la agricultura.
Vargas Gasca expuso “Biotechnological Production of Cytokinins by Trichoderma atroviride”, un proyecto que propone el uso de un sistema multigénico para que este hongo filamentoso produzca citoquininas, con aplicaciones biotecnológicas que podrían mejorar la productividad y tolerancia al estrés en plantas. El trabajo demuestra el potencial de los hongos del género Trichoderma para la producción de metabolitos de interés agrícola e industrial.
El Mtro. Vargas Gasca forma parte del Laboratorio de Interacción Planta-Microorganismo en la División de Ciencias Naturales y Exactas, liderado por la Bióloga y doctora en Ingeniería Genética de Plantas, Vianey Olmedo Monfil, profesora investigadora del Campus Guanajuato, que le ha brindado un acompañamiento científico, así como el espacio que le ha permitido desarrollar su investigación con el Trichoderma, un hongo benéfico ampliamente utilizado en agricultura.
Su trabajo consiste en la modificación genética para producir moléculas que normalmente sintetizan las plantas. “Le enseñamos al hongo a generar estas moléculas para su uso en la industria, con el fin de sustituir agroquímicos y pesticidas, y mejorar la productividad agrícola mediante alternativas más naturales y sustentables”, detalló.
Estas hormonas permiten a las plantas prepararse contra patógenos y condiciones adversas como la sequía, el calor o la salinidad del suelo, con lo cual se busca fortalecer la seguridad alimentaria, mediante soluciones accesibles y de bajo impacto ambiental.
El desarrollo se lleva a cabo en asociación estrecha con el Dr. Alfredo Herrera Estrella de la Unidad de Genómica Avanzada del Laboratorio Nacional de Genómica para la Biodiversidad del Centro de Investigación y de Estudios Avanzados del Instituto Politécnico Nacional (Langebio-CINVESTAV), e incluye colaboraciones con el Departamento de Ingeniería Química de la UG, así como con universidades nacionales como la Universidad de Guadalajara e internacionales, como la Universidad Técnica de Dinamarca, lo que ha permitido optimizar los procesos de producción desde la multidisciplinariedad. Hasta ahora, los resultados son prometedores.
“Al utilizar hongos filamentosos, nuestro sistema alcanza un rendimiento cerca de 2000 veces mayor que otros sistemas tradicionales como algas o bacterias. Esto permite proponerlo como un método de gran rendimiento y alta producción usando sustratos económicos, haciéndolo más accesible para el sector agrícola”, destacó Vargas Gasca.
De esta manera, al desarrollo científico se asocian los objetivos e impactos sociales, entre los que se encuentra acercar alternativas nuevas frente a los métodos tradicionales que han utilizado por mucho tiempo: “que estas investigaciones lleguen directamente a quien más lo necesita, que son los productores en nuestros campos y para ello buscamos de que tenga una aplicabilidad directa”, destacó.
Esto ayudaría, dijo, a tener mayor seguridad en las cosechas, por lo que desde este laboratorio universitario busca que estas investigaciones tengan aplicación real y directa para los productores mexicanos.
“Las problemáticas que viven los productores, como la falta de agua, motivaron mi deseo de que la investigación tenga un impacto social y no se quede solo en el laboratorio”, señaló.
Sobre su participación en el XV Congreso de Biología Molecular y Celular de Hongos, destacó la relevancia del encuentro organizado por la Sociedad Mexicana de Bioquímica, al reunir a especialistas de instituciones como el CINVESTAV, la Universidad Nacional Autónoma de México (UNAM), Instituto de Ecología A.C., (INECOL) e instituciones universitarias de todo el país. Además de contar con invitados de España, Dinamarca, Brasil y Estados Unidos. Se trata de uno de los foros más relevantes del país en el estudio de hongos.
Durante el encuentro se presentaron conferencias plenarias, avances de investigación y carteles científicos que evidencian el crecimiento del campo de la biología molecular de hongos. En este contexto, la participación del estudiante de la UG refuerza la presencia de la institución en espacios de alto nivel académico
Asimismo, el Maestro en Ciencias Francisco Vargas invitó a las y los jóvenes universitarios a acercarse a la ciencia desde etapas tempranas, en su experiencia, destacó la oportunidad que encontró en la UG mediante el programa institucional de Veranos de la Ciencia, vivencia que marcó su propio camino académico dentro de la Universidad de Guanajuato, donde ha realizado toda su formación desde el nivel medio superior.